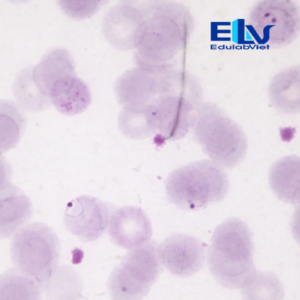
Tiêu bản ký sinh trùng sốt rét Plasmodium falciparum – Lam máu hiển vi chuẩn xét nghiệm

1. Giới thiệu sản phẩm
Tiêu bản ký sinh trùng sốt rét Plasmodium falciparum là tiêu bản hiển vi cố định được xử lý theo quy trình chuẩn phòng thí nghiệm, giúp bảo tồn rõ nét hình ảnh ký sinh trùng trong hồng cầu người. Sản phẩm phù hợp cho giảng dạy ký sinh trùng học, huyết học và đào tạo xét nghiệm y học.
2. Mô tả kỹ thuật tiêu bản cố định
Đây là tiêu bản hiển vi cố định: là tiêu bản hiển vi mà các tế bào gắn trên đó đã được xử lí qua rất nhiều công đoạn phức tạp như: cố định mẫu; phết máu lên lam kính; đem lam kính đi nhuộm (thường nhuộm Giemsa); khử nước; sấy khô mẫu; cố định mẫu vĩnh viễn bằng keo chuyên dụng và gắn lam phủ bảo vệ.
Chính vì vậy, tiêu bản hiển vi cố định thường có thời gian sử dụng rất lâu, có những tiêu bản có thể sử dụng lên đến vài chục năm nếu bảo quản tốt. Tuy nhiên, chất lượng màu sắc của tiêu bản sẽ giảm dần theo thời gian. Thời gian sử dụng tối ưu thường từ 3–5 năm. Nên thay tiêu bản mới khi màu sắc hoặc độ tương phản không còn đảm bảo cho việc quan sát chính xác.
-
Màu tế bào nhuộm đẹp, màu tiêu bản đậm và rõ nét, dễ dàng quan sát.
-
Có lam phủ bảo vệ mẫu, tăng độ bền và hạn chế ảnh hưởng từ môi trường.

3. Đặc điểm hình thái quan sát được
Dưới kính hiển vi quang học (vật kính dầu), có thể quan sát:
-
Thể nhẫn (ring form) đặc trưng trong hồng cầu
-
Một hồng cầu có thể chứa nhiều ký sinh trùng
-
Nhân ký sinh trùng bắt màu đậm, bào tương mảnh
-
Có thể thấy các thể phát triển tùy giai đoạn
Hình ảnh rõ nét giúp người học dễ dàng nhận diện và phân biệt với các loài Plasmodium khác.

4. Ứng dụng
-
Giảng dạy ký sinh trùng học – huyết học
-
Thực hành nhận diện ký sinh trùng sốt rét trong lam máu
-
Đào tạo kỹ thuật viên xét nghiệm
-
Minh họa bài học về bệnh sốt rét trong chương trình y sinh

Edulabviet
ĐC: 854/47/35 Thống Nhất, Phường 15, Quận Gò Vấp, Thành phố Hồ Chí Minh.
Hotline: 0937 527 787
Lượt Xem: 23



















Reviews
There are no reviews yet.